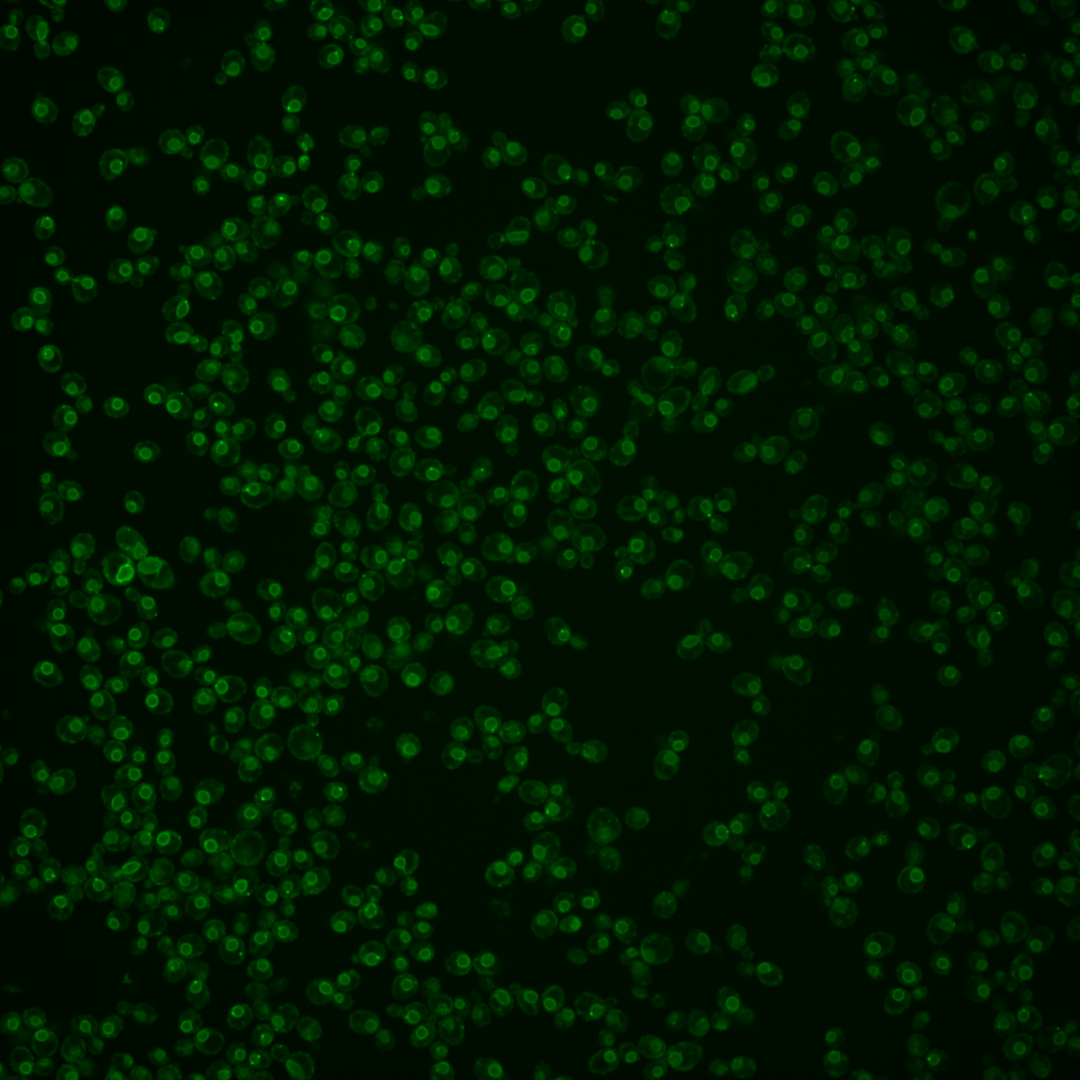

| Standard name | |
|---|---|
| Human Ortholog | |
| Description | Integral ER membrane protein with type-III transmembrane domains; required for maintenance of ER zinc homeostasis; necessary for efficient targeting of Trm1p tRNA methyltransferase to inner nuclear membrane; mutations cause defects in cortical ER morphology in both the mother and daughter cells |
Micrographs




















































































Sub-cellular Localization
Yeast GFP Assignment
Protein Abundance
Localization Change
External localization resources
| ensLOC | DeepLoc | |||||||||||||||||||||||
|---|---|---|---|---|---|---|---|---|---|---|---|---|---|---|---|---|---|---|---|---|---|---|---|---|
| Localization | WT1 | WT2 | WT3 | RAP60 | RAP140 | RAP220 | RAP300 | RAP380 | RAP460 | RAP540 | RAP620 | RAP700 | HU80 | HU120 | HU160 | rpd3Δ_1 | rpd3Δ_2 | rpd3Δ_3 | WT1 | WT2 | WT3 | AF100 | AF140 | AF180 |
| Cortical Patches | 2 | 1 | 2 | 0 | 3 | 0 | 15 | 17 | 14 | 14 | 18 | 23 | 3 | 3 | 4 | 10 | 0 | 2 | 1 | 1 | 11 | 2 | 5 | 1 |
| Bud | 0 | 0 | 0 | 2 | 0 | 5 | 6 | 8 | 17 | 13 | 19 | 25 | 0 | 0 | 0 | 2 | 0 | 0 | 1 | 1 | 0 | 1 | 1 | 1 |
| Bud Neck | 0 | 0 | 0 | 0 | 0 | 0 | 0 | 0 | 0 | 0 | 0 | 0 | 0 | 0 | 0 | 0 | 0 | 0 | 0 | 0 | 0 | 0 | 0 | 1 |
| Bud Site | 0 | 0 | 0 | 0 | 0 | 0 | 0 | 1 | 3 | 7 | 3 | 8 | 0 | 0 | 0 | 0 | 0 | 0 | – | – | – | – | – | – |
| Cell Periphery | 0 | 1 | 10 | 3 | 5 | 8 | 6 | 6 | 6 | 8 | 9 | 16 | 5 | 5 | 24 | 15 | 1 | 6 | 0 | 0 | 0 | 0 | 0 | 0 |
| Cytoplasm | 8 | 5 | 9 | 18 | 24 | 17 | 24 | 40 | 22 | 34 | 35 | 26 | 7 | 8 | 22 | 15 | 4 | 1 | 0 | 0 | 0 | 0 | 1 | 0 |
| Endoplasmic Reticulum | 91 | 58 | 107 | 82 | 107 | 85 | 151 | 139 | 95 | 84 | 124 | 99 | 46 | 59 | 118 | 3 | 0 | 0 | 173 | 88 | 317 | 89 | 136 | 148 |
| Endosome | 0 | 1 | 4 | 10 | 10 | 18 | 26 | 43 | 22 | 44 | 28 | 48 | 1 | 1 | 3 | 0 | 0 | 0 | 3 | 0 | 2 | 1 | 2 | 1 |
| Golgi | 8 | 0 | 21 | 7 | 9 | 1 | 6 | 5 | 1 | 0 | 3 | 1 | 2 | 1 | 1 | 17 | 8 | 10 | 0 | 0 | 4 | 2 | 1 | 0 |
| Mitochondria | 4 | 1 | 16 | 21 | 15 | 67 | 81 | 92 | 115 | 121 | 164 | 153 | 0 | 0 | 0 | 3 | 2 | 6 | 1 | 0 | 5 | 2 | 4 | 1 |
| Nucleus | 1 | 0 | 1 | 0 | 2 | 1 | 2 | 3 | 3 | 6 | 5 | 7 | 0 | 0 | 1 | 2 | 0 | 0 | 0 | 0 | 0 | 0 | 0 | 0 |
| Nuclear Periphery | 43 | 24 | 114 | 56 | 35 | 46 | 65 | 28 | 28 | 25 | 28 | 37 | 6 | 8 | 2 | 0 | 0 | 2 | 31 | 12 | 33 | 8 | 12 | 6 |
| Nucleolus | 0 | 0 | 2 | 2 | 3 | 9 | 18 | 20 | 22 | 32 | 47 | 55 | 0 | 0 | 0 | 0 | 0 | 1 | 0 | 0 | 0 | 0 | 0 | 0 |
| Peroxisomes | 0 | 0 | 0 | 0 | 0 | 1 | 1 | 1 | 2 | 4 | 2 | 4 | 0 | 0 | 0 | 0 | 0 | 0 | 0 | 0 | 0 | 0 | 0 | 0 |
| SpindlePole | 0 | 0 | 1 | 0 | 1 | 1 | 7 | 5 | 5 | 9 | 10 | 19 | 0 | 0 | 0 | 6 | 1 | 0 | 1 | 0 | 0 | 0 | 1 | 0 |
| Vac/Vac Membrane | 80 | 14 | 102 | 63 | 107 | 86 | 112 | 85 | 39 | 81 | 58 | 81 | 9 | 10 | 8 | 24 | 3 | 6 | 4 | 1 | 1 | 0 | 3 | 3 |
| Unique Cell Count | 186 | 81 | 287 | 213 | 262 | 275 | 406 | 403 | 308 | 388 | 419 | 459 | 64 | 79 | 156 | 74 | 18 | 25 | 221 | 109 | 378 | 110 | 173 | 170 |
| Labelled Cell Count | 237 | 105 | 389 | 264 | 321 | 345 | 520 | 493 | 394 | 482 | 553 | 602 | 79 | 95 | 183 | 97 | 19 | 34 | 221 | 109 | 378 | 110 | 173 | 170 |
Yeast GFP Assignment
Protein Abundance
| Screen | WT1 | WT2 | WT3 | RAP60 | RAP140 | RAP220 | RAP300 | RAP380 | RAP460 | RAP540 | RAP620 | RAP700 | HU80 | HU120 | HU160 | rpd3Δ_1 | rpd3Δ_2 | rpd3Δ_3 | AF100 | AF140 | AF180 |
|---|---|---|---|---|---|---|---|---|---|---|---|---|---|---|---|---|---|---|---|---|---|
| Mean Cell GFP Intensity (1e-4) | 13.1 | 13.5 | 12.0 | 11.6 | 10.9 | 9.3 | 9.7 | 9.7 | 9.1 | 8.8 | 8.9 | 9.1 | 11.9 | 11.5 | 12.0 | 11.7 | 15.1 | 16.4 | 12.2 | 13.1 | 14.1 |
| Std Deviation (1e-4) | 2.1 | 2.0 | 1.9 | 2.1 | 1.8 | 1.6 | 1.6 | 1.7 | 1.7 | 1.7 | 1.8 | 1.7 | 1.8 | 1.9 | 1.4 | 2.4 | 2.9 | 2.6 | 2.2 | 2.3 | 1.8 |
| Intensity Change (Log2) | – | – | – | -0.04 | -0.14 | -0.37 | -0.31 | -0.3 | -0.39 | -0.44 | -0.44 | -0.39 | -0.01 | -0.06 | 0.01 | -0.04 | 0.34 | 0.46 | 0.02 | 0.12 | 0.24 |
Localization Change
| Localization | RAP60 | RAP140 | RAP220 | RAP300 | RAP380 | RAP460 | RAP540 | RAP620 | RAP700 | HU80 | HU120 | HU160 | rpd3Δ_1 | rpd3Δ_2 | rpd3Δ_3 |
|---|---|---|---|---|---|---|---|---|---|---|---|---|---|---|---|
| Cortical Patches | 0 | 0 | 0 | 2.5 | 2.8 | 2.9 | 2.5 | 2.8 | 3.2 | 0 | 0 | 0 | 0 | 0 | 0 |
| Bud | 0 | 0 | 0 | 0 | 0 | 4.0 | 3.1 | 3.7 | 4.0 | 0 | 0 | 0 | 0 | 0 | 0 |
| Bud Neck | 0 | 0 | 0 | 0 | 0 | 0 | 0 | 0 | 0 | 0 | 0 | 0 | 0 | 0 | 0 |
| Bud Site | 0 | 0 | 0 | 0 | 0 | 0 | 0 | 0 | 0 | 0 | 0 | 0 | 0 | 0 | 0 |
| Cell Periphery | -1.4 | -1.1 | -0.4 | -1.7 | -1.7 | -1.2 | -1.1 | -1.1 | 0 | 0 | 0 | 4.5 | 5.1 | 0 | 0 |
| Cytoplasm | 2.6 | 3.0 | 1.7 | 1.7 | 3.4 | 2.2 | 3.0 | 2.8 | 1.6 | 0 | 0 | 4.3 | 0 | 0 | 0 |
| Endoplasmic Reticulum | 0.3 | 0.9 | -1.6 | 0 | -0.8 | -1.7 | -4.5 | -2.1 | -4.7 | 5.0 | 5.9 | 7.7 | -5.5 | -3.2 | -3.8 |
| Endosome | 2.2 | 1.8 | 3.1 | 3.2 | 4.8 | 3.4 | 5.0 | 3.3 | 4.7 | 0 | 0 | 0 | 0 | 0 | 0 |
| Golgi | -1.9 | -2.0 | -4.2 | -3.9 | -4.1 | -4.5 | -5.4 | -4.8 | -5.6 | 0 | 0 | -3.1 | 3.9 | 0 | 0 |
| Mitochondria | 1.8 | 0.1 | 6.3 | 5.4 | 6.1 | 9.3 | 8.2 | 10.1 | 8.8 | 0 | 0 | -3.0 | 0 | 0 | 0 |
| Nucleus | 0 | 0 | 0 | 0 | 0 | 0 | 0 | 0 | 0 | 0 | 0 | 0 | 0 | 0 | 0 |
| Nuclear Periphery | -3.1 | -6.9 | -6.0 | -7.0 | -10.5 | -8.8 | -10.6 | -10.8 | -10.5 | -4.6 | -4.9 | -8.8 | -6.6 | -3.4 | -3.1 |
| Nucleolus | 0 | 0 | 2.2 | 2.9 | 3.1 | 4.0 | 4.4 | 5.4 | 5.6 | 0 | 0 | 0 | 0 | 0 | 0 |
| Peroxisomes | 0 | 0 | 0 | 0 | 0 | 0 | 0 | 0 | 0 | 0 | 0 | 0 | 0 | 0 | 0 |
| SpindlePole | 0 | 0 | 0 | 0 | 0 | 0 | 0 | 0 | 3.1 | 0 | 0 | 0 | 0 | 0 | 0 |
| Vacuole | -1.4 | 1.3 | -1.1 | -2.2 | -4.2 | -6.6 | -4.2 | -6.8 | -5.5 | -3.3 | -3.9 | -7.1 | -0.5 | -1.6 | -1.2 |
External localization resources
Images






























Protein Concentration and Protein Localization Data
| R1 | R2 | R3 | ||||||||||||||||
|---|---|---|---|---|---|---|---|---|---|---|---|---|---|---|---|---|---|---|
| G1 Pre-START | G1 Post-START | S/G2 | Metaphase | Anaphase | Telophase | G1 Pre-START | G1 Post-START | S/G2 | Metaphase | Anaphase | Telophase | G1 Pre-START | G1 Post-START | S/G2 | Metaphase | Anaphase | Telophase | |
| Concentration | 8.8496 | 9.172 | 8.7303 | 8.6831 | 7.9633 | 9.018 | 11.8533 | 11.9969 | 11.3402 | 10.7714 | 11.6652 | 11.5715 | 11.1955 | 11.4196 | 11.4859 | 11.0696 | 11.312 | 11.1669 |
| Actin | 0.0077 | 0.0022 | 0.0081 | 0.0054 | 0.0013 | 0.0038 | 0.0006 | 0.0008 | 0.0002 | 0.0001 | 0.0004 | 0.0002 | 0.0051 | 0.0007 | 0.0005 | 0.0484 | 0.0031 | 0.0013 |
| Bud | 0.0001 | 0.0002 | 0.0001 | 0.0002 | 0.0001 | 0.0001 | 0 | 0 | 0 | 0 | 0 | 0 | 0.0001 | 0 | 0 | 0.0003 | 0.0001 | 0 |
| Bud Neck | 0.0006 | 0.0006 | 0.0004 | 0.0027 | 0.0021 | 0.0015 | 0.0001 | 0.0002 | 0 | 0.0003 | 0 | 0.0001 | 0.0002 | 0.0001 | 0.0002 | 0.0012 | 0.0004 | 0.0003 |
| Bud Periphery | 0.0002 | 0.0002 | 0.0001 | 0.0004 | 0.0002 | 0.0002 | 0.0001 | 0 | 0.0001 | 0.0001 | 0 | 0 | 0.0001 | 0.0001 | 0 | 0.0008 | 0.0003 | 0.0001 |
| Bud Site | 0.0003 | 0.0038 | 0.0006 | 0.0007 | 0.0003 | 0.0001 | 0.0001 | 0.0001 | 0 | 0 | 0 | 0 | 0.0002 | 0 | 0 | 0.0011 | 0.0001 | 0 |
| Cell Periphery | 0.0002 | 0.0006 | 0.0003 | 0.0005 | 0.0002 | 0.0002 | 0.0002 | 0.0028 | 0.0002 | 0.0006 | 0.0001 | 0.0002 | 0.0004 | 0.0008 | 0.0004 | 0.0011 | 0.0002 | 0.0002 |
| Cytoplasm | 0.0124 | 0.0512 | 0.0271 | 0.0289 | 0.0103 | 0.0152 | 0.0016 | 0.0052 | 0.0013 | 0.0015 | 0.0009 | 0.0005 | 0.007 | 0.0033 | 0.0064 | 0.0034 | 0.0024 | 0.0008 |
| Cytoplasmic Foci | 0.005 | 0.0068 | 0.0054 | 0.01 | 0.0044 | 0.0008 | 0.0012 | 0.0012 | 0.0003 | 0.0001 | 0.0005 | 0.0002 | 0.0042 | 0.0008 | 0.0007 | 0.0069 | 0.0014 | 0.0003 |
| Eisosomes | 0.0001 | 0 | 0.0005 | 0 | 0 | 0 | 0.0001 | 0 | 0 | 0 | 0 | 0 | 0.0001 | 0 | 0 | 0.0004 | 0.0001 | 0 |
| Endoplasmic Reticulum | 0.2762 | 0.5547 | 0.6361 | 0.6323 | 0.4806 | 0.4346 | 0.5776 | 0.7467 | 0.8426 | 0.948 | 0.7507 | 0.5778 | 0.4487 | 0.6868 | 0.8078 | 0.795 | 0.5816 | 0.5463 |
| Endosome | 0.0248 | 0.0193 | 0.0177 | 0.0285 | 0.028 | 0.0061 | 0.008 | 0.0076 | 0.0037 | 0.0039 | 0.0044 | 0.002 | 0.0214 | 0.0075 | 0.0064 | 0.0123 | 0.0214 | 0.0062 |
| Golgi | 0.0045 | 0.0026 | 0.0024 | 0.0092 | 0.0032 | 0.0013 | 0.0015 | 0.0014 | 0.0006 | 0.0002 | 0.0012 | 0.0006 | 0.0062 | 0.0027 | 0.0012 | 0.0071 | 0.0065 | 0.002 |
| Lipid Particles | 0.0236 | 0.0191 | 0.0143 | 0.0096 | 0.0331 | 0.0089 | 0.0132 | 0.0268 | 0.0065 | 0.001 | 0.0057 | 0.0104 | 0.0128 | 0.046 | 0.0143 | 0.0085 | 0.0126 | 0.006 |
| Mitochondria | 0.007 | 0.0006 | 0.0016 | 0.0028 | 0.011 | 0.0009 | 0.0016 | 0.0002 | 0.0007 | 0.0002 | 0.0005 | 0.0002 | 0.0011 | 0.0005 | 0.0002 | 0.0022 | 0.0021 | 0.0004 |
| None | 0.0007 | 0.0005 | 0.0082 | 0.0002 | 0.0013 | 0.0003 | 0.004 | 0.0001 | 0.0003 | 0 | 0.0001 | 0.0001 | 0.003 | 0.0002 | 0.0001 | 0.002 | 0.0004 | 0.0003 |
| Nuclear Periphery | 0.5642 | 0.2725 | 0.2257 | 0.2401 | 0.3475 | 0.4566 | 0.3679 | 0.1944 | 0.1361 | 0.0326 | 0.2245 | 0.3966 | 0.4383 | 0.2356 | 0.1507 | 0.0942 | 0.323 | 0.4181 |
| Nucleolus | 0.0043 | 0.0011 | 0.004 | 0.0001 | 0.0005 | 0.0023 | 0.0003 | 0.0001 | 0 | 0 | 0 | 0 | 0.0007 | 0 | 0 | 0.0001 | 0.0003 | 0 |
| Nucleus | 0.0388 | 0.0309 | 0.0234 | 0.0149 | 0.0586 | 0.0472 | 0.0042 | 0.0018 | 0.0009 | 0.0008 | 0.0043 | 0.003 | 0.0162 | 0.002 | 0.0025 | 0.0016 | 0.0244 | 0.0062 |
| Peroxisomes | 0.0024 | 0.0002 | 0.0082 | 0.0003 | 0.0004 | 0.0007 | 0.0002 | 0 | 0 | 0 | 0 | 0 | 0.0013 | 0 | 0 | 0.0021 | 0.0001 | 0 |
| Punctate Nuclear | 0.0062 | 0.0135 | 0.0043 | 0.001 | 0.0018 | 0.0055 | 0.002 | 0.0026 | 0.0001 | 0 | 0.0008 | 0.0003 | 0.017 | 0.0004 | 0.0005 | 0.0031 | 0.0052 | 0.0005 |
| Vacuole | 0.0067 | 0.0139 | 0.006 | 0.0067 | 0.0077 | 0.0063 | 0.006 | 0.0038 | 0.0025 | 0.0094 | 0.0016 | 0.0015 | 0.005 | 0.0048 | 0.0034 | 0.0031 | 0.0047 | 0.0023 |
| Vacuole Periphery | 0.0139 | 0.0055 | 0.0055 | 0.0052 | 0.0075 | 0.0074 | 0.0096 | 0.0043 | 0.0038 | 0.0014 | 0.0042 | 0.0063 | 0.0109 | 0.0079 | 0.0046 | 0.0051 | 0.0097 | 0.0086 |
Sequencing Data
| R1 | R2 | |||||||||
|---|---|---|---|---|---|---|---|---|---|---|
| G1 Post-START | S/G2 | Metaphase | Anaphase | Telophase | G1 Post-START | S/G2 | Metaphase | Anaphase | Telophase | |
| Gene Expression | 26.9123 | 28.0676 | 29.2575 | 30.3572 | 30.0467 | 17.1845 | 28.0413 | 31.4673 | 27.7332 | 34.1005 |
| Translational Efficiency | 0.5716 | 0.486 | 0.5156 | 0.4347 | 0.4538 | 0.9387 | 0.5078 | 0.4557 | 0.5464 | 0.4503 |
Hit Data
| Dataset | Hit |
|---|---|
| Protein Concentration | ✘ |
| Protein Localization | ✔ |
| Gene Expression | ✘ |
| Translational Efficiency | ✘ |
Endocytosis
| Temp | Actin Patch (Sac6-tdTomato) | Cortical Patch (Sla1-GFP) | Late Endosome (Snf7-GFP) | Vacuole (Vph1-GFP) |
|---|---|---|---|---|
| 37℃ | ||||
| RT |
Cell Cycle Omics
CYCLoPs (Ice2-GFP)
| Gene / Allele | Actin Patch (Sac6-tdTomato) | Cortical Patch (Sla1-GFP) | Late Endosome (Snf7-GFP) | Vacuole (Sac6-tdTomato) |
|---|
| Gene | Images |
|---|
| Gene | Images |
|---|
Images are not yet available
Images are not yet available